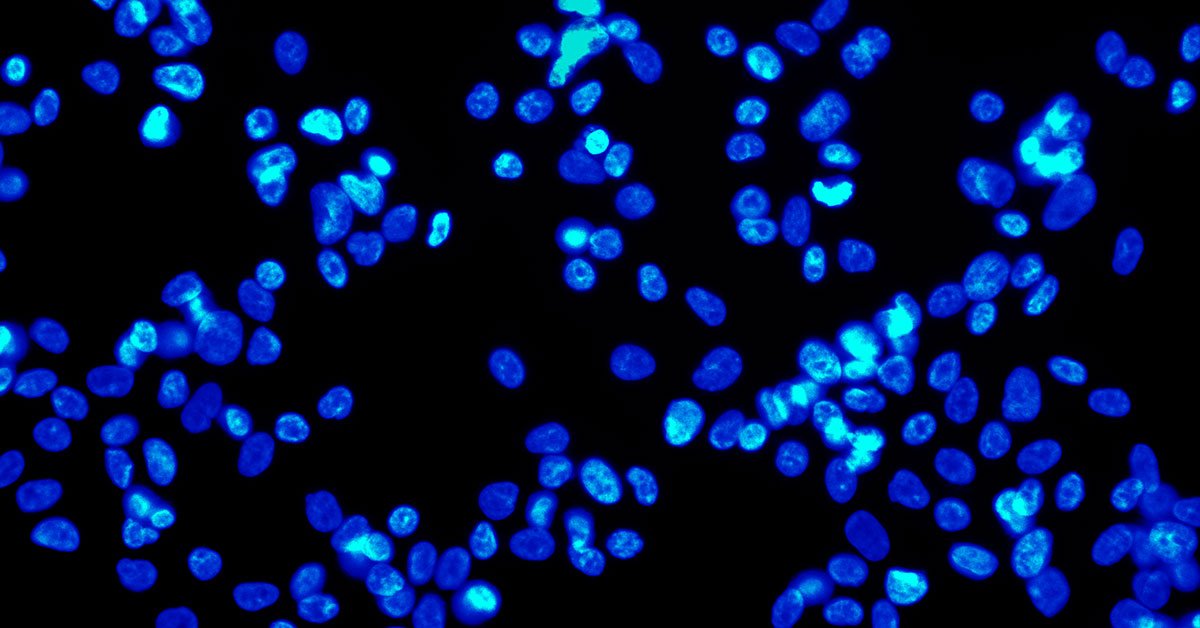
1.jpg

研究和诊断生物医学应用通常需要成像仪具备较高的空间分辨率、准确的色彩还原度以及弱光条件下较高的灵敏度,而且许多情况需要同时具备这三种因素,才能提高数据可靠性。选择适当的显微镜学摄像头、组织学摄像头、细胞学/细胞遗传学摄像头、落射荧光摄像头,对于临床应用进行正确诊断或研究工作提供可靠数据具有至关重要的作用。那么要怎么知道什么样的机器视觉摄像头最适合您的应用呢? 以下章节涵盖了为生物医学和生命科学应用选择机器视觉摄像头时需要考虑的方面。
要考虑的应用特定因素
分辨率与色彩精度
所需的分辨率取决于样品中目标结构相对于摄像头像素大小的放大率;也就是说,显微镜应用的高分辨率可以通过 2MP、25MP 或介于这两者之间的摄像头来实现。它取决于光学元件对样品中目标结构进行的相对于摄像头像素大小的放大率;为了选出能实现所需分辨率的最佳摄像头,首先要确定待解析样本中最小结构的尺寸。然后将其乘以光学系统中的镜头放大率。从而得出投射到摄像头传感器上的结构的尺寸。
如果结构的尺寸至少是摄像头传感器上像素的 2.33(尼奎斯特)倍大小,那么摄像头可以解析此机构。例如,如果这些投射的结构的尺寸是 ~8um,那么 3.45um 像素的摄像头可以解析这些结构。测量分辨率还可以用其他方法(如线对数),但上述方法可以通过简单计算,找到用于测试的最佳摄像头选项。
组织学、细胞学和细胞遗传学等成像应用使用较大范围白光(~400 nm 至 700 nm),或使用此范围内的一种选定波长(例如,565 nm)。如果这批样品中的样本不是活动的(即固定不动的),则可以暴露于亮光下,不会有污渍褪色或样品被杀死的风险。这种情况下,摄像头的主要要求是高分辨率和色彩还原度。反过来说,弱光灵敏度不是一个重要因素。如需查找高分辨率型号,请使用我们的 FLIR 机器视觉摄像头选择器筛选并排列百万像素。
灵敏度、量子效率及动态范围
使用活体样本的成像应用的挑战是避免样本在太强光线下过度曝光,否则会使荧光分子褪色或杀死样本。这些应用通常使用一种称为落射荧光的技术。落射荧光技术可用于固定样本和活体样本。有的标本很难获得或价格昂贵,而且制作样本的材料和人工费用很高。因此,能保护样品质量的系统有助于降低这些成像应用的持续成本。
落射荧光使用经过过滤的高能量波长,以刺激样品发出低能量波长。低能量波长再经过过滤返回相机。这种情况下,可以对样品使用强度和破坏性强较弱的光线,因此最大的要求是灵敏度。即便发射光能量较低,具有出色灵敏度的照相机也可以提供高质量的图像。

如需查找具备出色灵敏度、在弱光条件下性能良好的型号,您可以侧重于以下三种技术规格:绝对灵敏度、量子效率以及动态范围。绝对灵敏度就是得到相当于传感器所观测噪声之信号所需的光子数,值越小越好。量子效率是指给定波长下转化为电子的光子——值越高越好。动态范围是信号与噪声(包括颞暗噪声)比值,颞暗噪声是指无信号时传感器内的噪声,动态范围值越高越好。若要轻松比对,请使用 FLIR 型号选择器筛选并查找最高值。
通常单色型号的弱光性能优于彩色型号。如需查看某型号的成像性能详情,请阅读该型号的详细 EMVA 成像性能文档。每个摄像头系列的这些文档位于 FLIR 网页“摄像头资源”链接:Oryx 资源、Blackfly S USB 资源、Blackfly S GigE 资源、 Firefly 资源。
关于 EMVA 成像性能标准及对比型号灵敏度的方法,请参阅如何评估摄像头灵敏度。
因素综合
对于同时使用白光和落射荧光的应用,请查找拥有 Sony 全新转换增益功能的摄像头型号,此功能可以优化传感器,实现高灵敏度或高饱和容量。弱光环境首选较高的转换增益,因为在此条件下,读取噪声被更大程度地弱化,从而产生较低的绝对灵敏度阈值,非常适合在短时曝光下检测弱信号。强光条件下饱和容量得到了最大化,获得的动态范围得以增强,因此稍低的转换增益是这种情况的理想选择。最大动态范围将受限于 12 位 ADC。
若要再次查找带转换功能的型号列表,请参阅我们的《机器视觉传感器综述》。如需帮助您选择适合特定应用的摄像头,请联系我们的一位机器视觉专家。
选择最适合的摄像头
选择摄像头时,较新的 CMOS 传感器是个很好的出发点。较新的传感器通常性能更好(价格可能还更低)。 另外,如果针对的应用需要在几年内购买多个摄像头(如持续生产诊断仪器),那么就要选择生命周期不会很快结束的摄像头——否则可能要承受提前设计替换摄像头的费用。
FLIR 生产的机器视觉摄像头变型有超过 200 多种,广泛应用于采用最新 CMOS 传感器的三大系列:Blackfly S、Oryx 和 Firefly。

Blackfly S 系摄像头的传感器、外形尺寸及接口最为广泛。这些摄像头提供 USB3 和 GigE 型号,功能广泛,设计初期易于整合。板级 Blackfly S 型号是全功能盒装产品的微型版本,特别适合空间受限和嵌入式的应用。其功能广泛,性价比高,分辨率最高可达 24MP,是生物医学和生命科学应用的首选。

Oryx 摄像头系列拥有适配最快 10GigE 接口的高分辨率传感器,能够以 60FPS 的速度捕捉 4K 分辨率、12 位的图像。Oryx 的 10GBASE-T 接口是经过证明且广泛部署的标准,能够在线缆长度超过 50 米的经济实惠的 CAT6A 上或者长度超过 30 米的 CAT5e 上提供可靠的图像传输。

Firefly 摄像头系列的外壳尺寸娇小、重量轻、功耗低且价格实惠。Firefly DL 型号还能够运行已经过训练的神经网络,可用于物体检测或分类。
所有 FLIR 机器视觉彩色摄像头都可以通过不同的白平衡选项的形式自定义色彩还原,并使用特殊色彩校正矩阵,这对于生物医学成像非常重要,医学成像中,色彩的准确度的涵义不同,取决于人类对诊断的视觉分析以及实现数据准确性的机器可读格式之间的对比。关于这些功能的更多信息,请参阅 “应用 Blackfly S 和 Spinnaker 的白平衡”以及“应用 Blackfly S 和 Oryx 的色彩校正”。
另外,FLIR 机器视觉 Blackfly S、Oryx 和 Firefly 摄像头系列可通过 GenICam3 及 Spinnaker SDK 进行控制和编程,它们自一开始设计时就以轻松开发与部署为理念时,确保我们能更快进行应用开发和测试。
如需进一步缩小摄像头型号选择,可使用 FLIR 网站的机器视觉摄像头选择器,其中多个可用的筛选条件包括:
